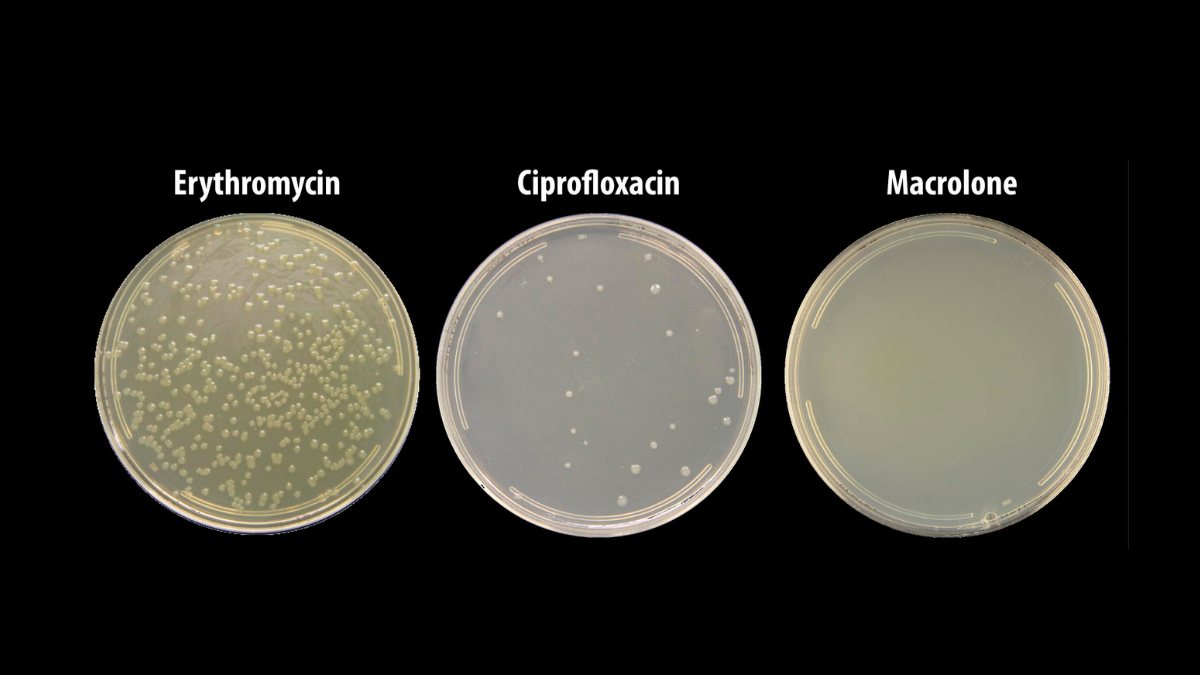

En un estudio reciente publicado en la revista Nature Chemical Biology, investigadores de la Universidad de Illinois Chicago y el Instituto de Tecnología de Beijing han desarrollado una nueva clase de antibióticos llamada macrolones. Estos medicamentos atacan dos procesos bacterianos simultáneamente, y los científicos detrás de un nuevo estudio dicen que esto hace que la evolución de la resistencia sea 100 millones de veces más difícil.
La resistencia antibiótica es una amenaza creciente para la salud humana. En 2019, la Organización Mundial de la Salud estimó que la resistencia antimicrobiana fue responsable directa de 1.27 millones de muertes en todo el mundo, y la situación sigue empeorando. Incluso se ha plantado un escenario de apocalipsis antibiótico. Este problema ha incentivado a los investigadores para desarrollar nuevos antibioticos que puedan detener este problema.

Y puede que los macrolones sean lo que estábamos buscando. Este tipo de antibiótico funciona mediante un ataque dual que hace casi imposible que las bacterias desarrollen resistencia. Estos compuestos sintéticos combinan dos tipos de antibióticos ampliamente utilizados: los macrólidos y las fluoroquinolonas. Los macrólidos, como la eritromicina, bloquean el ribosoma bacteriano, impidiendo que las bacterias fabriquen las proteínas necesarias para su funcionamiento. Por otro lado, las fluoroquinolonas, como el ciprofloxacino, atacan una enzima bacteriana llamada ADN girasa, lo que impide que el ADN de las bacterias adquiera la estructura correcta.
«La belleza de este antibiótico es que mata a través de dos objetivos diferentes en las bacterias,» explicó Alexander Mankin, autor principal, en un comunicado. «Si el antibiótico actúa sobre ambos objetivos a la misma concentración, entonces las bacterias pierden su capacidad de volverse resistentes mediante la adquisición de mutaciones aleatorias en cualquiera de los dos objetivos.»
Al combinar estas dos estrategias en un solo compuesto, los macrolones pueden atacar simultáneamente el ribosoma y la ADN girasa. Este enfoque hace que sea extremadamente difícil para las bacterias desarrollar una defensa genética simple y efectiva contra el antibiótico. Incluso cuando las bacterias han evolucionado una mutación de resistencia que normalmente protegería contra los macrólidos tradicionales, algunos macrolones pueden seguir siendo efectivos.

Crédito de la imagen: Dmitrii Travin
«El resultado principal de todo este trabajo es la comprensión de cómo necesitamos avanzar,» dijo Mankin. «Y el entendimiento que estamos proporcionando a los químicos es que deben optimizar estos macrolones para que ataquen ambos objetivos”.
Aún se requiere más desarrollo de estos compuestos prometedores antes de que puedan ser ampliamente utilizados en el tratamiento de infecciones bacterianas. Sin embargo, este descubrimiento marca un paso significativo hacia la creación de fármacos que puedan superar la resistencia bacteriana y proteger la salud pública a largo plazo.
https://doi.org/10.1038/s41589-024-01685-3
Related
Descubre más desde Cerebro Digital
Suscríbete y recibe las últimas entradas en tu correo electrónico.